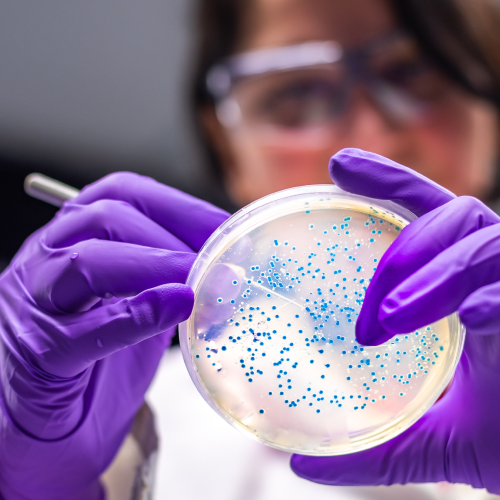

IN THE COURT OF CHANCERY OF THE STATE OF DELAWARE
TIMOTHY MCCANTS, LAURENȚIU OVIDIU
CERNAHOSCHI, and THOMAS JOSEPH, on behalf of themselves and all similarly situated stockholders,
Plaintiffs,
v.
GEOFFREY STRONG, OLIVIA WASSENAAR, WILSON HANDLER, CHRISTINE HOMMES, JOSEPH ROMEO, JAN WILSON, JOHN STICE, BARRY EDINBURG, SPARTAN ACQUISITION SPONSOR II LLC, APOLLO GLOBAL MANAGEMENT, INC., AP SPARTAN ENERGY HOLDINGS II, L.P., FTV-SUNLIGHT, INC., and TIGER CO-INVEST BSUNLIGHT BLOCKER, LLC,
Defendants.
|
|
SUMMARY NOTICE OF PENDENCY AND PROPOSED SETTLEMENT OF STOCKHOLDER CLASS ACTION, SETTLEMENT HEARING, ANDRIGHT TO APPEAR
TO: All Persons who held shares of Spartan Acquisition Corp. II (“Spartan”) Class A common stock asof 5:00 PM EDT on July 6, 2021 (the “Redemption Deadline”), either of record or beneficially, and who did not redeem all of their shares, including their successors in interest who obtained their shares by operation of law, but excluding the Excluded Persons (as defined in the Stipulation and the Notice) (the “Class”).1
PLEASE READ THIS SUMMARY NOTICE CAREFULLY. YOUR RIGHTS WILL BE AFFECTED BY A CLASS ACTION LAWSUIT PENDING IN THIS COURT.
YOU ARE HEREBY NOTIFIED, pursuant to an Order of the Court of Chancery of the State of Delaware (the “Court”), that the above-captioned stockholder class action (the “Action”) is pending in the Court.
YOU ARE ALSO NOTIFIED that (i) plaintiffs Timothy McCants, Laurenṭiu Ovidiu Cernahoschi, and Thomas Joseph (“Plaintiffs”), individually and on behalf of the Class; and (ii) defendants Geoffrey Strong, Olivia Wassenaar, Wilson Handler, Christine Hommes, Joseph Romeo, Jan Wilson, John Stice, Spartan Acquisition Sponsor II LLC, Apollo Global Management, Inc., AP Spartan Energy Holdings II, L.P. (collectively the “Spartan Defendants”), and Barry Edinburg(collectively with the Spartan Defendants, “Defendants,” and Defendants together with Plaintiff, the“Parties,” and each a “Party”), have reached a proposed cash settlement for $8,000,000 in total (the “Settlement Amount”). The Settlement, if approved, will resolve all claims in the Action against the Defendants. A copy of the Settlement is available at www.SpartanDeSPACStockholderSettlement.com.
A hearing (the “Settlement Hearing”) will be held on May 1, 2026 at 11:00 a.m., before The Honorable
Paul A. Fioravanti, Jr., Vice Chancellor, either in person at the Court of Chancery of the State of Delaware, Leonard
L. Williams Justice Center, 500 North King Street, Wilmington, Delaware, 19801, or remotely by telephone or videoconference (in the discretion of the Court), to, among other things: (i) determine whether to finally certify the Class for settlement purposes only, pursuant to Court of Chancery Rules23(a), 23(b)(1), and 23(b)(2); (ii) determine whether Plaintiffs and Plaintiffs’ Counsel have adequately represented the Class, and whether Plaintiffs should be finally appointed as Class representatives for the Class and Plaintiffs’ Counsel should be finally appointed as Class counsel for the Class; (iii) determine whether the proposed Settlement should be approved as fair, reasonable, and adequate to the Class and inthe best interests of the Class; (iv) determine whether the Action should be dismissed with prejudice and the Releases provided under the Stipulation should be granted; (v) determine whether the Order and FinalJudgment approving the Settlement should be entered; (vi) determine whether the proposed Plan of Allocation
1 Any capitalized terms used in this Summary Notice that are not otherwise defined in this Summary Notice shall have the meanings given to them in the Stipulation and Agreement of Settlement, Compromise, and Release, dated December 8, 2025 (the “Stipulation” or “Settlement”). Copies of the Stipulation and the full Notice of Pendency and Proposed Settlement of Stockholder Class Action, Settlement Hearing, and Right to Appear (the “Notice”) are available at the Settlement website: www.SpartanDeSPACStockholderSettlement.com.
of the Net Settlement Fund is fair and reasonable, and should therefore be approved; (vii) determine whether and in what amount any Fee and Expense Award should be paid to Plaintiffs’ Counsel out of theSettlement Fund; (viii) hear and rule on any objections to the Settlement, the proposed Plan of Allocation, and/or Plaintiffs’ Counsel’s application for a Fee and Expense Award; and (ix) consider any other matters that may properly be brought before the Court in connection with the Settlement. Any updates regarding the Settlement Hearing, including any changes to the date or time of the hearing or updates regarding in-person or remote appearances at the hearing, will be posted to the Settlement website, www.SpartanDeSPACStockholderSettlement.com.
If you are a member of the Class, your rights will be affected by the pending Action and theSettlement, and you may be entitled to share in the Net Settlement Fund. If you have not yet received the Notice, you may obtain a copy of the Notice by contacting the Settlement Administrator at Spartan Stockholder Settlement, c/o Epiq Systems, Inc., PO Box 2258, Portland, OR 97208-2258. A copy of the Notice can also be downloaded from the Settlement website, www.SpartanDeSPACStockholderSettlement.com.
If the Settlement is approved by the Court and the Effective Date occurs, the Net Settlement Fund will be distributed on a pro rata basis to Eligible Class Members in accordance with the terms of the proposed Plan of Allocation stated in the Notice or such other plan of allocation as is approved by theCourt. Pursuant to the proposed Plan of Allocation, each Eligible Class Member will be eligible to receivea pro rata payment from the Net Settlement Fund equal to the product of (a) the Net Settlement Fund; and(b) a fraction, the numerator of which is the number of Eligible Shares held by the Eligible Class Member, and the denominator of which is a number representing the total number of Eligible Shares. As explainedin further detail in the Notice at Paragraphs 41-47, Eligible Class Members do not have to submit a claim form to receive a payment from the Settlement.
Any objections to the Settlement, the proposed Plan of Allocation, or Plaintiffs’ Counsel’s application for the Fee and Expense Award must be filed with the Register in Chancery in the Court of Chancery of the State of Delaware and delivered to Plaintiffs’ Counsel and Defendants’ Counsel such that they are received no later than April 17, 2026, in accordance with the instructions set forth in the Notice.
Please do not contact the Court or the Office of the Register in Chancery regarding this Summary Notice. All questions about this Summary Notice, the Settlement, or your eligibility to participate in the Settlement should be directed to the Settlement Administrator or Plaintiffs’ Counsel.
Requests for the Notice should be made to the Settlement Administrator:
Spartan StockholderSettlement c/o Epiq Systems, Inc.
PO Box 2258
Portland, OR 97208-2258
Inquiries, other than requests for the Notice, should be made to Plaintiffs’ Counsel:
Tiffany Geyer Lydon, Esq. Ashby & Geddes, P.A.
500 Delaware Avenue, 8thFloor Wilmington, DE 19899 [email protected]
BY ORDER OF THE COURTOF CHANCERY OF THESTATE OF DELAWARE:
Dated: February 27, 2026